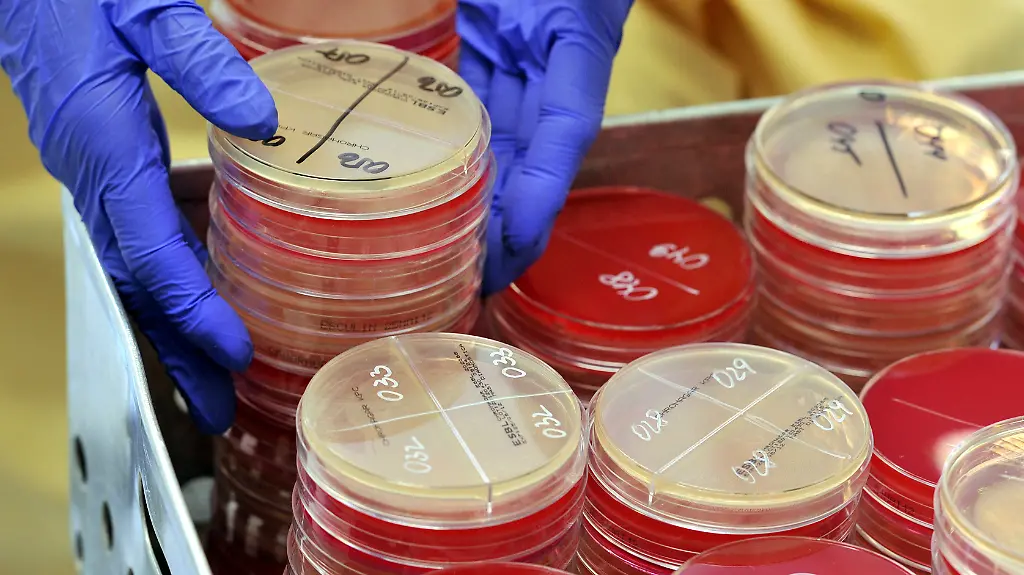
antibiotikum

Wirken nicht bei Virus-InfektionÄrzte setzen zu oft Antibiotika ein
Antibiotika können Wunder wirken - manchmal werden sie jedoch völlig falsch verordnet. Dann bilden sich mitunter resistente Erreger, gegen die das Antibiotikum nichts mehr ausrichten kann. Ärzte verschreiben das Medikament noch immer viel zu oft.
Der Kampf gegen das unnötige Verschreiben und Einnehmen von Antibiotika zeigt Erfolge - ist aber noch lange nicht am Ziel. Niedergelassene Ärzte verordneten im vergangenen Jahr 27 Prozent der erkältungsbedingt krankgeschriebenen Beschäftigten Antibiotika.
2008 war noch in 38 Prozent der Fälle das Medikament verschrieben worden. Das geht aus Vorabdaten des aktuellen Gesundheitsreports der Techniker Krankenkasse hervor. "Diese Trendwende geht in die richtige Richtung", sagte Tim Steimle von der TK. Dennoch sollten Ärzte und Patienten bei dem Thema nicht lockerlassen. "Die überwiegende Zahl der Erkältungsinfekte ist durch Viren hervorgerufen - und gegen eine Virus-Infektion hilft das Medikament nicht." Beim falschen Einsatz von Antibiotika können sich multiresistente Erreger bilden, gegen die das Medikament dann nicht mehr wirkt.
Auch Gesundheitsminister Hermann Gröhe warnt vor sorglosem Einsatz des Medikaments. "Wenn Antibiotika nicht mehr wirken, bricht eine tragende Säule unserer Gesundheitsversorgung weg", sagte der CDU-Politiker in Berlin. Gröhe spricht Ärzten im Kampf gegen den unbedachtem Einsatz eine Schlüsselrolle zu. Allerdings bräuchte es auch in der Bevölkerung ein stärkeres Bewusstsein dafür, "dass Antibiotika nicht bei jedem Husten oder einer tropfenden Nase helfen".
Kampf soll international fortgeführt werden
Besonders stark ist der Verordnungsrückgang laut TK-Daten bei jenen Patienten, die nur kurz krankgeschrieben waren. 2016 erhielten etwa 19 Prozent von ihnen Antibiotika, 2008 waren es noch gut 30 Prozent. Gröhe fordert im Kampf gegen Resistenzen globales Handeln. Ein wichtiger Fortschritt sei, dass man sich beim G20-Treffen der Gesundheitsminister darauf verständigt habe, internationale Forschungspartnerschaften stärker zu fördern.
Der Rückgang der Antibiotika-Verschreibungen fällt laut TK mit der Entwicklung der Deutschen Antibiotika-Resistenzstrategie (DART) 2008 zusammen. 2015 hat die Bundesregierung diese Strategie weiterentwickelt und DART 2020 verabschiedet, mit der unter anderem schärfer gegen den Missbrauch von Antibiotika vorgegangen werden soll. Das Forschungsministerium fördert die Antibiotikaforschung mit rund 30 Millionen Euro im Jahr.